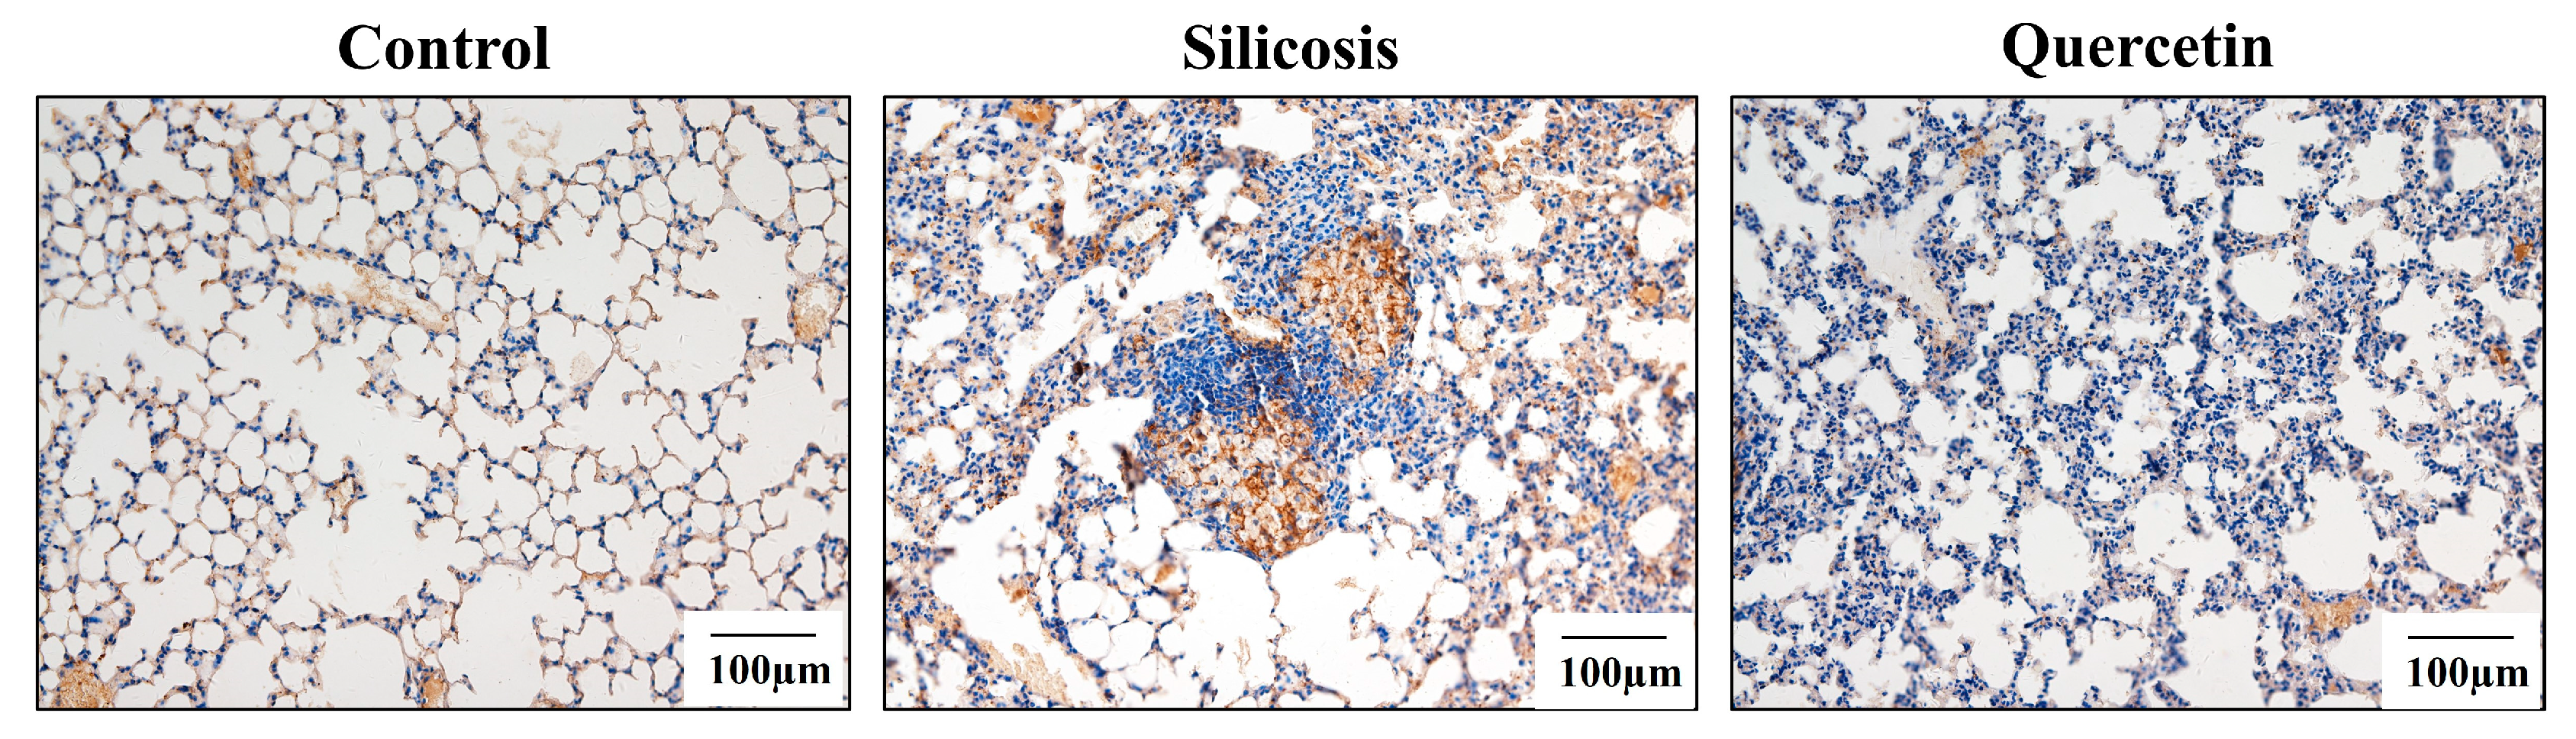
Cimb 45 00202 g005 Cimb 45 00202 g005

Quercetin Alleviates Pulmonary Fibrosis in Silicotic Mice by Inhibiting Macrophage Transition and TGF-β-Smad2/3 Pathway
Abstract
1. Introduction
2. Materials and Methods
2.1. Animal Models
2.2. Cell Culture
2.3. Non-Invasive Measurement of the Pulmonary Function
2.4. Hematoxylin–Eosin Staining
2.5. Van Gieson’s Staining
2.6. Immunohistochemical and Immunocytochemical Staining
2.7. Immunofluorescent Staining
2.8. Western Blot
2.9. Statistical Analysis
3. Results
3.1. Quercetin Treatment Inproved Lung Functions and Inhibited Collagen Deposition
3.2. Inhibitory Effect of Quercetin on Macrophage Transition in the Lungs of Silicotic Mice
3.3. Quercetin Inhibited SiO2-Induced Macrophage Transition
3.4. Quercetin Regulated TGF-β-Smad2/3 Pathway
4. Discussion
5. Conclusions
Author Contributions
Funding
Institutional Review Board Statement
Informed Consent Statement
Data Availability Statement
Conflicts of Interest
References
- Ryan, F.H.; Daniel, C.C. Silica-related diseases in the modern world. Allergy 2020, 75, 2805–2817. [Google Scholar]
- Li, T.; Yang, X.; Xu, H.; Liu, H. Early Identification, Accurate Diagnosis, and Treatment of Silicosis. Can. Respir. J. 2022, 2022, 3769134. [Google Scholar] [CrossRef]
- Hasan, A.A.; Tatarskiy, V.; Kalinina, E. Synthetic Pathways and the Therapeutic Potential of Quercetin and Curcumin. Int. J. Mol. Sci. 2022, 23, 14413. [Google Scholar] [CrossRef] [PubMed]
- Maugeri, A.; Calderaro, A.; Patanè, G.T.; Navarra, M.; Barreca, D.; Cirmi, S.; Felice, M.R. Targets Involved in the Anti-Cancer Activity of Quercetin in Breast, Colorectal and Liver Neoplasms. Int. J. Mol. Sci. 2023, 24, 2952. [Google Scholar] [CrossRef] [PubMed]
- Mohammed, H.A.; Sulaiman, G.M.; Anwar, S.S.; Tawfeeq, A.T.; Khan, R.A.; Mohammed, S.A.; Al-Omar, M.S.; Alsharidah, M.; Rugaie, O.A.; Al-Amiery, A.A. Quercetin against MCF7 and CAL51 breast cancer cell lines: Apoptosis, gene expression and cytotoxicity of nano-quercetin. Nanomedicine 2021, 16, 1937–1961. [Google Scholar] [CrossRef] [PubMed]
- Aslam, A.; Sheikh, N.; Shahzad, M.; Saeed, G.; Fatima, N.; Akhtar, T. Quercetin ameliorates thioacetamide-induced hepatic fibrosis and oxidative stress by antagonizing the Hedgehog signaling pathway. J. Cell. Biochem. 2022, 123, 1356–1365. [Google Scholar] [CrossRef]
- Rahmani, A.H.; Alsahli, M.A.; Khan, A.A.; Almatroodi, S.A. Quercetin, a Plant Flavonol Attenuates Diabetic Complications, Renal Tissue Damage, Renal Oxidative Stress and Inflammation in Streptozotocin-Induced Diabetic Rats. Metabolites 2023, 13, 130. [Google Scholar] [CrossRef] [PubMed]
- Albadrani, G.M.; BinMowyna, M.N.; Bin-Jumah, M.N.; El–Akabawy, G.; Aldera, H.; Al-Farga, A.M. Quercetin prevents myocardial infarction adverse remodeling in rats by attenuating TGF-β1/Smad3 signaling: Different mechanisms of action. Saudi J. Biol. Sci. 2021, 28, 2772–2782. [Google Scholar] [CrossRef] [PubMed]
- Takano, M.; Deguchi, J.; Senoo, S.; Izumi, M.; Kawami, M.; Yumoto, R. Suppressive effect of quercetin against bleomycin-induced epithelial-mesenchymal transition in alveolar epithelial cells. Drug Metab. Pharmacokinet. 2020, 35, 522–526. [Google Scholar] [CrossRef] [PubMed]
- Geng, F.; Xu, M.; Zhao, L.; Zhang, H.; Li, J.; Jin, F.; Li, Y.; Li, T.; Yang, X.; Li, S. Quercetin Alleviates Pulmonary Fibrosis in Mice Exposed to Silica by Inhibiting Macrophage Senescence. Front. Pharmacol. 2022, 13, 912029. [Google Scholar] [CrossRef] [PubMed]
- Kishore, A.; Petrek, M. Roles of Macrophage Polarization and Macrophage-Derived miRNAs in Pulmonary Fibrosis. Front. Immunol. 2021, 12, 678457. [Google Scholar] [CrossRef]
- Kulle, A.; Thanabalasuriar, A.; Cohen, T.S.; Szydlowska, M. Resident macrophages of the lung and liver: The guardians of our tissues. Front. Immunol. 2022, 13, 1029085. [Google Scholar] [CrossRef]
- Finicelli, M.; Digilio, F.A.; Galderisi, U.; Peluso, G. The Emerging Role of Macrophages in Chronic Obstructive Pulmonary Disease: The Potential Impact of Oxidative Stress and Extracellular Vesicle on Macrophage Polarization and Function. Antioxidants 2022, 11, 494. [Google Scholar] [CrossRef]
- Tang, P.M.K.; Nikolic-Paterson, D.J.; Lan, H.Y. Macrophages: Versatile players in renal inflammation and fibrosis. Nat. Reviews. Nephrol. 2019, 15, 144–158. [Google Scholar] [CrossRef]
- Wang, S.; Meng, X.M.; Ng, Y.Y.; Ma, F.Y.; Zhou, S.; Zhang, Y.; Yang, C.; Huang, X.R.; Xiao, J.; Wang, Y.Y.; et al. TGF-β/Smad3 signalling regulates the transition of bone marrow-derived macrophages into myofibroblasts during tissue fibrosis. Oncotarget 2016, 7, 8809–8822. [Google Scholar] [CrossRef]
- Wang, Y.Y.; Jiang, H.; Pan, J.; Huang, X.R.; Wang, Y.C.; Huang, H.F.; To, K.F.; Nikolic-Paterson, D.J.; Lan, H.Y.; Chen, J.H. Macrophage-to-Myofibroblast Transition Contributes to Interstitial Fibrosis in Chronic Renal Allograft Injury. J. Am. Soc. Nephrol. 2017, 28, 2053–2067. [Google Scholar] [CrossRef] [PubMed]
- Yang, F.; Chang, Y.; Zhang, C.; Xiong, Y.; Wang, X.; Ma, X.; Wang, Z.; Li, H.; Shimosawa, T.; Pei, L.; et al. UUO induces lung fibrosis with macrophage-myofibroblast transition in rats. Int. Immunopharmacol. 2021, 93, 107396. [Google Scholar] [CrossRef]
- Li, Y.; Jin, F.; Li, T.; Yang, X.; Cai, W.; Li, S.; Gao, X.; Mao, N.; Liu, H.; Xu, H.; et al. Minute Cellular Nodules as Early Lesions in Rats with Silica Exposure via Inhalation. Vet. Sci. 2022, 9, 251. [Google Scholar] [CrossRef] [PubMed]
- Xu, H.; Song, X.D.; Li, Y.; Dai, J. The new method of cells growing on the glass slide. Chin. J. Appl. Physiol. 2009, 25, 283–285. [Google Scholar]
- Verma, S.; Dutta, A.; Dahiya, A.; Kalra, N. Quercetin-3-Rutinoside alleviates radiation-induced lung inflammation and fibrosis via regulation of NF-κB/TGF-β1 signaling. Phytomedicine Int. J. Phytother. Phytopharm. 2022, 99, 154004. [Google Scholar] [CrossRef]
- Sari, E.; He, C.; Margaroli, C. Plasticity towards Rigidity: A Macrophage Conundrum in Pulmonary Fibrosis. Int. J. Mol. Sci. 2022, 23, 11443. [Google Scholar] [CrossRef] [PubMed]
- Marrocco, A.; Ortiz, L.A. Role of metabolic reprogramming in pro-inflammatory cytokine secretion from LPS or silica-activated macrophages. Front. Immunol. 2022, 13, 936167. [Google Scholar] [CrossRef]
- Misharin, A.V.; Morales-Nebreda, L.; Reyfman, P.A.; Cuda, C.M.; Walter, J.M.; McQuattie-Pimentel, A.C.; Chen, C.I.; Anekalla, K.R.; Joshi, N.; Williams, K.J.; et al. Monocyte-derived alveolar macrophages drive lung fibrosis and persist in the lung over the life span. J. Exp. Med. 2017, 214, 2387–2404. [Google Scholar] [CrossRef] [PubMed]
- Tang, P.C.T.; Chung, J.Y.F.; Xue, V.W.W.; Xiao, J.; Meng, X.M.; Huang, X.R.; Zhou, S.; Chan, A.S.W.; Tsang, A.C.M.; Cheng, A.S.L.; et al. Smad3 Promotes Cancer-Associated Fibroblasts Generation via Macrophage–Myofibroblast Transition. Adv. Sci. 2022, 9, e2101235. [Google Scholar] [CrossRef]
- Xiong, Y.; Chang, Y.; Hao, J.; Zhang, C.; Yang, F.; Wang, Z.; Liu, Y.; Wang, X.; Mu, S.; Xu, Q. Eplerenone Attenuates Fibrosis in the Contralateral Kidney of UUO Rats by Preventing Macrophage-to-Myofibroblast Transition. Front. Pharmacol. 2021, 12, 620433. [Google Scholar] [CrossRef] [PubMed]
- Feng, Y.; Guo, F.; Mai, H.; Liu, J.; Xia, Z.; Zhu, G.; Zhang, J.; Ma, L.; Fu, P. Pterostilbene, a Bioactive Component of Blueberries, Alleviates Renal Interstitial Fibrosis by Inhibiting Macrophage-Myofibroblast Transition. Am. J. Chin. Med. 2020, 48, 1715–1729. [Google Scholar] [CrossRef]
- Jun, H.L.; Joan, M. TGF-β in developmental and fibrogenic EMTs. Semin. Cancer Biol. 2022, 86 Pt 2, 136–145. [Google Scholar]
- Sánchez-Jaramillo, E.A.; Gasca-Lozano, L.E.; Vera-Cruz, J.M.; Hernández-Ortega, L.D.; Gurrola-Díaz, C.M.; Bastidas-Ramírez, B.E.; Vargas-Guerrero, B.; Mena-Enríquez, M.; Martínez-Limón, F.D.J.; Salazar-Montes, A.M. Nanoparticles Formulation Improves the Antifibrogenic Effect of Quercetin on an Adenine-Induced Model of Chronic Kidney Disease. Int. J. Mol. Sci. 2022, 23, 5392. [Google Scholar] [CrossRef]
- Boutanquoi, P.M.; Burgy, O.; Beltramo, G.; Bellaye, P.S.; Dondaine, L.; Marcion, G.; Pommerolle, L.; Vadel, A.; Spanjaard, M.; Demidov, O.; et al. TRIM33 prevents pulmonary fibrosis by impairing TGF-β1 signalling. Eur. Respir. J. 2020, 55, 1901346. [Google Scholar] [CrossRef]

Disclaimer/Publisher’s Note: The statements, opinions and data contained in all publications are solely those of the individual author(s) and contributor(s) and not of MDPI and/or the editor(s). MDPI and/or the editor(s) disclaim responsibility for any injury to people or property resulting from any ideas, methods, instructions or products referred to in the content. |
© 2023 by the authors. Licensee MDPI, Basel, Switzerland. This article is an open access article distributed under the terms and conditions of the Creative Commons Attribution (CC BY) license (https://creativecommons.org/licenses/by/4.0/).
Share and Cite
Geng, F.; Zhao, L.; Cai, Y.; Zhao, Y.; Jin, F.; Li, Y.; Li, T.; Yang, X.; Li, S.; Gao, X.; et al. Quercetin Alleviates Pulmonary Fibrosis in Silicotic Mice by Inhibiting Macrophage Transition and TGF-β-Smad2/3 Pathway. Curr. Issues Mol. Biol. 2023, 45, 3087-3101. https://doi.org/10.3390/cimb45040202
Geng F, Zhao L, Cai Y, Zhao Y, Jin F, Li Y, Li T, Yang X, Li S, Gao X, et al. Quercetin Alleviates Pulmonary Fibrosis in Silicotic Mice by Inhibiting Macrophage Transition and TGF-β-Smad2/3 Pathway. Current Issues in Molecular Biology. 2023; 45(4):3087-3101. https://doi.org/10.3390/cimb45040202
Chicago/Turabian StyleGeng, Fei, Lan Zhao, Yuhao Cai, Ying Zhao, Fuyu Jin, Yaqian Li, Tian Li, Xinyu Yang, Shifeng Li, Xuemin Gao, and et al. 2023. "Quercetin Alleviates Pulmonary Fibrosis in Silicotic Mice by Inhibiting Macrophage Transition and TGF-β-Smad2/3 Pathway" Current Issues in Molecular Biology 45, no. 4: 3087-3101. https://doi.org/10.3390/cimb45040202
APA StyleGeng, F., Zhao, L., Cai, Y., Zhao, Y., Jin, F., Li, Y., Li, T., Yang, X., Li, S., Gao, X., Cai, W., Mao, N., Sun, Y., Xu, H., Wei, Z., & Yang, F. (2023). Quercetin Alleviates Pulmonary Fibrosis in Silicotic Mice by Inhibiting Macrophage Transition and TGF-β-Smad2/3 Pathway. Current Issues in Molecular Biology, 45(4), 3087-3101. https://doi.org/10.3390/cimb45040202

